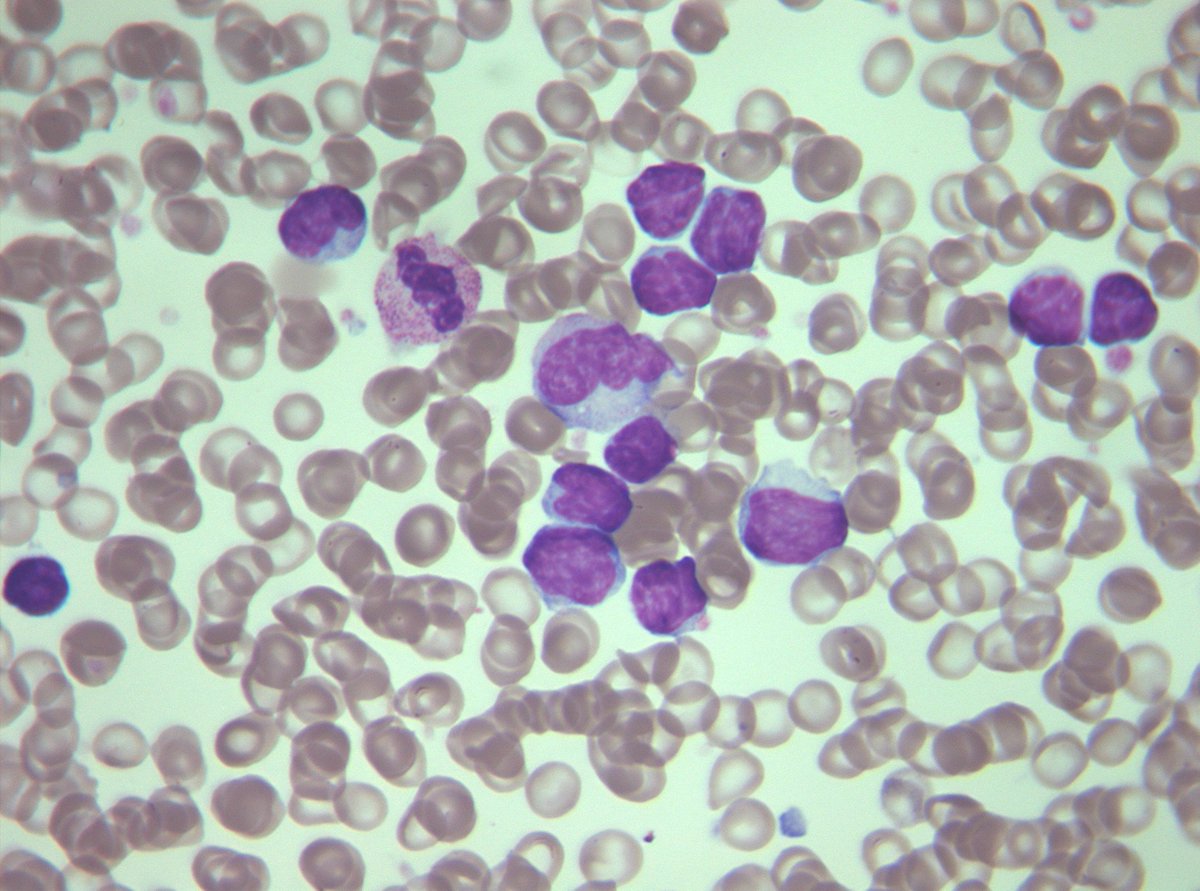

Лимфоциты — ключевые клетки иммунной системы, защищающие организм от инфекций и заболеваний. В статье рассмотрим норму лимфоцитов в крови у детей по возрасту и представим таблицу для удобства. Узнаете, как правильно сдавать анализы на лимфоциты, меры предостережения от отклонений, а также что такое лимфоцитоз и лимфопения и их причины. Эта информация поможет родителям лучше понимать здоровье детей и своевременно реагировать на проблемы.
Виды лимфоцитов и роль в организме
Человеческая кровь состоит из форменных элементов, среди которых выделяются красные и белые кровяные клетки. Белые клетки, в свою очередь, подразделяются на эозинофилы, моноциты, базофилы, нейтрофилы и лимфоциты. Эти показатели служат основой для анализа функционирования иммунной системы.
Лимфоциты составляют около 30% от общего числа форменных элементов крови. Эти белые кровяные клетки образуются в костном мозге и вилочковой железе, а также в периферических органах. Они играют ключевую роль в борьбе с воспалительными процессами средней тяжести, не уничтожаются при взаимодействии с патогенными агентами и поддерживают уровень иммунной защиты на протяжении длительного времени.
Нормальный уровень лимфоцитов в крови необходим для полноценного функционирования защитной системы организма. Основные функции этих клеток включают:
- распознавание и нейтрализацию инфекционных агентов;
- активацию иммунной памяти и выработку иммунного ответа;
- уничтожение атипичных клеток;
- противовоспалительное действие;
- стимуляцию регенерации тканей на клеточном уровне;
- синтез антител;
- обнаружение и капсулирование антигенов.
Лимфоциты делятся на несколько типов. Большинство из них формируются в органах иммунной системы и перемещаются по кровеносным сосудам и лимфатическим путям. Основные категории лимфоцитов можно разделить на две группы:
- Крупные гранулярные клетки, включая лимфобласты, иммунобласты и NK-клетки, размером от 10 до 18 мкм.
- Малые лимфоциты — В и Т клетки, размером от 6,5 до 8,3 мкм.
При оценке уровня лимфоцитов в крови у детей особое внимание уделяется показателям Т и В клеток. Они подразделяются на киллеры — регуляторы иммунной системы, хелперы — способствующие синтезу антител, супрессоры — активирующие работу хелперов, и эффекторы — ускоряющие защитные реакции. Функции лимфоцитов активизируются в ответ на воспалительные процессы, что приводит к образованию новых клеток памяти иммунной системы, обеспечивая тем самым выработку иммунитета.

Нормальные показатели лимфоцитов у детей варьируются в зависимости от возраста, и врачи подчеркивают важность их мониторинга для оценки состояния иммунной системы. В первые месяцы жизни уровень лимфоцитов может достигать 60-70% от общего числа лейкоцитов, что связано с формированием иммунной защиты. С возрастом этот показатель постепенно снижается. К 6 годам нормой считается 30-50%, а в подростковом возрасте — 20-40%. Врачи отмечают, что отклонения от этих значений могут указывать на различные заболевания, включая инфекции или иммунные расстройства. Регулярные анализы крови помогают своевременно выявить проблемы и принять необходимые меры для поддержания здоровья ребенка.

Для чего проверяют количество лимфоцитов
Отдельно уровень белых кровяных клеток не измеряется. Он устанавливается путем анализа общей лейкоцитарной формулы. Специалисты рекомендуют проводить не общий, а развернутый анализ крови, если есть подозрения на аутоиммунные заболевания или нарушения в работе кроветворной и лимфатической систем.
Контроль уровня лимфоцитов у детей особенно важен при длительных воспалительных и инфекционных процессах различного происхождения, чтобы оценить эффективность проводимого лечения. Изменения в этом показателе могут свидетельствовать о возможных внутренних кровотечениях, сепсисе, аллергических реакциях или последствиях радиационного воздействия.
Важно!
Показатели могут отклоняться от нормы у детей, рожденных от матерей, которые испытывали серьезные трудности во время беременности.
| Возраст | Норма лимфоцитов (абсолютное число, x10^9/л) | Норма лимфоцитов (относительное число, %) |
|---|---|---|
| Новорожденные (до 1 месяца) | 2.0 — 11.0 | 40 — 70 |
| 1 месяц — 1 год | 4.0 — 10.5 | 45 — 75 |
| 1 год — 2 года | 3.0 — 9.5 | 40 — 70 |
| 2 года — 4 года | 2.5 — 8.0 | 35 — 65 |
| 4 года — 6 лет | 2.0 — 7.0 | 30 — 60 |
| 6 лет — 10 лет | 1.5 — 6.0 | 25 — 55 |
| 10 лет — 16 лет | 1.2 — 5.2 | 20 — 50 |
Как сдают анализы
Для определения уровня лимфоцитов у ребенка кровь обычно берут из пальца. Исключение составляют новорожденные и дети до одного года, которые отстают в физическом развитии и имеют недостаточный вес. В таких случаях кровь берут из пяточки. Ранее эта процедура могла вызывать значительный дискомфорт, однако современные лаборатории используют вакуумные системы, что значительно уменьшает болезненные ощущения.
Как правило, результаты анализа становятся известны уже на следующий день. В некоторых лабораториях же результаты могут быть готовы всего через 4 часа. Это время вполне достаточно для получения количественных показателей.

Лабораторная диагностика
На лабораторное стекло наносят каплю крови. Ранее лаборанту приходилось вручную определять процентное соотношение лимфоцитов к общему количеству лейкоцитов, однако в современных лабораториях эту задачу выполняет компьютер.
При наличии органических заболеваний лимфоциты претерпевают изменения: их форма становится «рваной», размеры могут как увеличиваться, так и уменьшаться, а клетки одного типа по-разному реагируют на красители. Если уровень лимфоцитов у ребенка выходит за пределы нормы, назначается повторный анализ, в рамках которого отдельно измеряют уровень иммуноглобулинов и всех типов белых кровяных клеток. Это позволяет более точно установить диагноз.
Подготовка к анализу
Для получения точных результатов анализов кровь следует сдавать «на голодный желудок». Новорожденным кровь берут сразу после рождения, а грудным детям и малышам до года достаточно не кормить их за 2-3 часа до визита в лабораторию. Это ограничение не вызывает трудностей, так как интервал между кормлениями в этом возрасте составляет 3-4 часа.
Атипичные мононуклеары в общем анализе крови. Мононуклеары – это клетки с одним ядром, такие как моноциты и лимфоциты. Их также называют…
Когда дети начинают питаться «взрослой» пищей, родителям следует в течение 2 дней до сдачи анализов изменить рацион. Необходимо избегать жареных блюд, солений, сладостей и газированных напитков. Игнорирование этих рекомендаций может привести к получению недостоверных результатов.
На уровень форменных элементов крови могут влиять стрессы, возбуждение, физическая активность и прием медикаментов. Если ребенок недавно перенес болезнь, рекомендуется подождать 2 недели после завершения лечения перед сдачей анализов. В случае необходимости регулярного приема лекарств важно сообщить об этом врачу, который назначает анализ, и сотрудникам лаборатории.
Сколько раз проводят диагностику
Не стоит обижаться на врача, если он рекомендует сдать анализ повторно или несколько раз. Это не является попыткой «выкачать деньги» или признаком некомпетентности. Подобная необходимость может возникнуть для уточнения диагноза, особенно если после болезни появились осложнения, или для оценки эффективности лечения — возможно, потребуется внести изменения в терапию. Конечно, нельзя полностью исключать человеческий фактор: недостоверные результаты могут быть получены из-за нарушений в процессе забора крови или транспортировки, ошибок при анализе, поломки оборудования или неправильной подготовки пациента к исследованию.
Важно!
Ложноположительный результат может возникнуть при резкой смене положения тела или повышенном волнении перед процедурой. Поэтому крайне важно подготовить детей к диагностике и обеспечить их спокойствие.
Уровень лимфоцитов по возрасту
Показатели лимфоцитов изменяются на протяжении жизни и зависят от возраста и пола пациента. В таблице представлены усредненные данные для детей, которые колеблются в зависимости от внеутробной адаптации, перехода от грудного вскармливания к искусственному, а также от введения «взрослой» пищи, формирования органов и гормонального развития:
| Возраст | Нормальный уровень лимфоцитов, % |
| новорожденные | 12-36 |
| 1-6 месяцев | 39-75 |
| 6-12 месяцев | 43-73%, оптимальным считается 50-52 |
| от 1 до 2 лет | 38-72 |
| от 2 до 4-6 лет | 25-60 |
| 7-12 лет | 23-53 |
| 12-15 лет | 25-48 |
В анализах крови уровень лимфоцитов у детей обычно указывается в виде чисел, умноженных на 10 в девятой степени:
- для детей до года — 2-11;
- 1-2 года — 3-9,5;
- 2-4 года — 2-8;
- 5-10 лет — 1,5-6,8;
- 10-16 лет — 1,2-5,2.
В дальнейшем расчет показателя осуществляется аналогично взрослым, с учетом пола пациента и физиологических характеристик. На уровень лимфоцитов могут влиять физические нагрузки, беременность, переход в менопаузу, а также, возможно, профессия и условия труда. Иногда показатели рассчитываются более точно для детей в возрасте 5 лет, 8-9 лет и так далее.
Повышение уровня лимфоцитов
Лимфоцитоз представляет собой значительное увеличение уровня лимфоцитов в крови. Он может быть абсолютным, когда наблюдается рост общего числа лимфоцитов, или относительным, когда их процент в лейкоцитарной формуле увеличивается за счет снижения доли нейтрофилов, что указывает на перераспределение клеточных элементов крови.
Симптоматика лимфоцитоза часто схожа с проявлениями инфекционной интоксикации: это может быть озноб, повышение температуры, сонливость, общая слабость и вялость. Также возможно поражение дыхательных путей и появление кожных высыпаний. При реактивном лимфоцитозе могут увеличиваться селезенка и печень, нарушаться функция почек, а лимфоузлы могут опухать. Если причина остается невыясненной в течение длительного времени, у детей может наблюдаться задержка психофизического развития, а у младенцев — опасное снижение веса.
Причины, способствующие увеличению лимфоцитов:
- инфекционные болезни различной природы — корь, скарлатина, ветряная оспа, ОРВИ, туберкулез, аденовирус;
- аутоиммунные и онкологические заболевания;
- аллергические реакции;
- отравления;
- операция по удалению селезенки — спленэктомия;
- токсоплазмоз;
- гельминтозы;
- гиперфункция щитовидной железы.
Лимфоцитоз может развиваться на фоне эмоционального стресса, хронической усталости, а также неправильного или недостаточного питания. На уровень лимфоцитов также могут влиять длительное применение противоэпилептических, гормональных препаратов, антидепрессантов и средств, поддерживающих иммунную систему.
Снижения уровня лимфоцитов
При снижении уровня лимфоцитов ниже нормальных значений у ребенка устанавливается диагноз лимфопения. Данная проблема чаще всего наблюдается у детей младше 6 лет, так как в этом возрасте иммунная система только начинает формироваться. Защитные функции организма еще не полностью развиты, а кроветворная система может функционировать с перегрузкой при наличии заболеваний.
Лимфопения может быть выявлена у младенцев, чьи родители имеют в анамнезе такие заболевания, как ВИЧ или СПИД, туберкулез, злокачественные опухоли и наследственные иммунные расстройства. Уровень белых кровяных клеток может снижаться также при заболеваниях почек, активной форме туберкулеза и нарушениях обмена веществ, связанных с нехваткой витаминов группы В или белковых продуктов.
Важно!
Родителям, придерживающимся вегетарианского питания, следует помнить, что, независимо от их личных убеждений, не стоит ограничивать детей в потреблении животного белка. Это может негативно сказаться на общем развитии ребенка и ослабить его иммунную систему.
Профилактика
В некоторых ситуациях отклонение уровня лимфоцитов от нормальных значений может проходить незаметно и выявляться только в ходе анализов. В таких случаях также важно установить причину изменений и вернуть показатели в норму, чтобы детский организм мог адекватно реагировать на внедрение инфекционных или чуждых агентов.
Причины повышения моноцитов в крови у ребенкаМоноциты — это клетки иммунной системы, которые играют ключевую роль в поддержании гомеостаза (внутреннего равновесия организма). Если…
Общие профилактические меры. Рекомендуется закалять ребенка, избегать перегрева и переохлаждения, а также правильно составлять рацион — в нем должны присутствовать белковые продукты, свежие овощи, фрукты и ягоды. Не стоит отказываться от прививок — вакцинацию следует проводить в соответствии с возрастом. Важно, чтобы родители не занимались самолечением и обращались за медицинской помощью при первых признаках ухудшения состояния.
Причины отклонений от нормы
Отклонения уровня лимфоцитов у детей могут быть вызваны различными факторами, которые могут как указывать на наличие заболеваний, так и быть следствием физиологических процессов. Важно понимать, что лимфоциты — это ключевые клетки иммунной системы, отвечающие за защиту организма от инфекций и других патогенов. Поэтому любые изменения в их количестве могут иметь серьезные последствия для здоровья ребенка.
Одной из основных причин повышения уровня лимфоцитов (лимфоцитоз) является инфекция. Вирусные инфекции, такие как грипп, корь, ветряная оспа и другие, часто приводят к увеличению числа лимфоцитов, так как организм активирует иммунный ответ для борьбы с вирусами. Бактериальные инфекции, такие как туберкулез или инфекционный мононуклеоз, также могут вызывать лимфоцитоз, хотя в таких случаях чаще наблюдается увеличение других типов белых кровяных клеток.
Кроме инфекционных заболеваний, лимфоцитоз может быть связан с хроническими воспалительными процессами, такими как аллергические реакции или аутоиммунные заболевания. В этих случаях лимфоциты могут увеличиваться в ответ на постоянное раздражение или повреждение тканей организма.
С другой стороны, снижение уровня лимфоцитов (лимфопения) может быть вызвано рядом факторов. Одной из наиболее распространенных причин является иммунодефицит, который может быть как врожденным, так и приобретенным. Врожденные иммунодефициты могут проявляться в раннем возрасте и требовать специального лечения. Приобретенные иммунодефициты могут возникать в результате вирусных инфекций, таких как ВИЧ, или в результате воздействия определенных медикаментов, например, химиотерапии.
Также лимфопения может быть следствием тяжелых заболеваний, таких как рак, или хронических заболеваний, которые истощают иммунную систему. В некоторых случаях снижение уровня лимфоцитов может быть связано с недостаточным питанием или дефицитом витаминов, таких как витамин B12 или фолиевая кислота.
Важно отметить, что любые отклонения от нормы требуют внимательного анализа и консультации с врачом. Лимфоциты играют критическую роль в поддержании здоровья ребенка, и их уровень должен находиться под контролем. Регулярные медицинские обследования и анализы крови помогут своевременно выявить возможные проблемы и принять необходимые меры для их устранения.
Симптомы нарушений уровня лимфоцитов
Нарушения уровня лимфоцитов у детей могут проявляться различными симптомами, которые могут варьироваться в зависимости от причины изменения их количества. Лимфоциты – это важные клетки иммунной системы, отвечающие за защиту организма от инфекций и заболеваний. Поэтому любые отклонения от нормы могут сигнализировать о наличии проблем со здоровьем.
Одним из наиболее распространенных симптомов низкого уровня лимфоцитов (лимфопения) является повышенная восприимчивость к инфекциям. Дети с низким уровнем лимфоцитов могут чаще болеть простудами, гриппом и другими инфекционными заболеваниями. У них могут наблюдаться частые и затяжные инфекции, которые требуют более длительного лечения.
С другой стороны, высокий уровень лимфоцитов (лимфоцитоз) также может вызывать определенные симптомы. В некоторых случаях это может быть связано с вирусными инфекциями, такими как мононуклеоз или гепатит. Дети с лимфоцитозом могут испытывать общую слабость, усталость, а также могут жаловаться на головные боли и боли в горле.
Кроме того, изменения в уровне лимфоцитов могут сопровождаться другими симптомами, такими как:
- Лихорадка – повышение температуры тела может указывать на наличие инфекции.
- Увеличение лимфатических узлов – может быть признаком активной иммунной реакции.
- Кожные высыпания – могут возникать при некоторых инфекционных заболеваниях или аллергических реакциях.
- Потеря аппетита и снижение веса – могут быть связаны с хроническими инфекциями или другими заболеваниями.
Важно отметить, что наличие одного или нескольких из этих симптомов не всегда указывает на проблемы с уровнем лимфоцитов. Для точной диагностики и определения причин изменений в количестве лимфоцитов необходимо обратиться к врачу и провести соответствующие анализы. Специалист сможет оценить состояние здоровья ребенка и при необходимости назначить лечение.
Регулярные медицинские осмотры и анализы крови помогут своевременно выявить отклонения в уровне лимфоцитов и предотвратить развитие серьезных заболеваний. Родителям следует быть внимательными к состоянию здоровья своих детей и не игнорировать любые изменения в их самочувствии.
Методы коррекции уровня лимфоцитов
Коррекция уровня лимфоцитов у детей может быть необходима в случае, если результаты анализа крови показывают отклонения от нормы. Лимфоциты играют ключевую роль в иммунной системе, и их уровень может варьироваться в зависимости от возраста, состояния здоровья и других факторов. Существует несколько методов, которые могут помочь нормализовать уровень лимфоцитов.
1. Правильное питание. Один из основных способов поддержания нормального уровня лимфоцитов — это сбалансированное питание. В рацион ребенка должны входить продукты, богатые витаминами и минералами, особенно витаминами A, C, D и E, а также цинком и селеном. Эти вещества способствуют укреплению иммунной системы и поддержанию нормального уровня лимфоцитов. Важно включать в рацион свежие фрукты и овощи, цельнозерновые продукты, нежирные белки и здоровые жиры.
2. Физическая активность. Регулярные физические нагрузки способствуют улучшению общего состояния здоровья и укреплению иммунной системы. Умеренные физические упражнения, такие как прогулки на свежем воздухе, плавание или занятия спортом, могут помочь поддерживать нормальный уровень лимфоцитов. Однако важно учитывать возраст и физическую подготовку ребенка, чтобы избежать чрезмерных нагрузок.
3. Устранение стресса. Стресс может негативно влиять на уровень лимфоцитов, поэтому важно создавать для ребенка комфортную и спокойную обстановку. Методы релаксации, такие как йога, медитация или просто время, проведенное с семьей, могут помочь снизить уровень стресса и, как следствие, нормализовать уровень лимфоцитов.
4. Лечение заболеваний. Если отклонения в уровне лимфоцитов связаны с определенными заболеваниями, такими как инфекции или аутоиммунные расстройства, необходимо обратиться к врачу для назначения соответствующего лечения. В некоторых случаях может потребоваться применение иммуномодуляторов или других медикаментов, которые помогут восстановить нормальный уровень лимфоцитов.
5. Вакцинация. Вакцинация играет важную роль в поддержании иммунной системы и может помочь предотвратить инфекции, которые могут привести к изменению уровня лимфоцитов. Следует следить за графиком прививок и консультироваться с педиатром по вопросам вакцинации.
Важно помнить, что любые меры по коррекции уровня лимфоцитов должны проводиться под контролем врача. Самолечение может привести к нежелательным последствиям, поэтому при обнаружении отклонений в анализах крови необходимо обратиться за медицинской помощью для получения рекомендаций и назначения лечения.